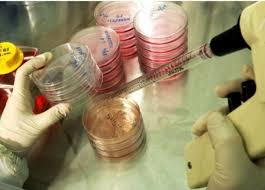
تقنية تجميد البويضات

وافقت “الهيئة العامة للرقابة المالية” اليوم بصفة مبدئية على قيام شركة “العبور للاستثمار العقارى” بنشر الدعوة لقدامى المساهمين للاكتتاب فى اسهم زيادة راس مال الشركة المصدر وقدرها 22 مليون جنيه، لعدد 4.4 مليون سهم بقيمة اسمية 5 جنيهات للسهم الواحد بالاضافة الى مبلغ 12.5 قرش مصاريف اصدار عن كل سهم مع السماح بتداول حق الاكتتاب منفصلا عن السهم الاصلى .
أوضحت البورصة أن صاحب الحق في الاكتتاب هم المساهمين القدامى بالشركة حاملي ومشتري السهم حتى نهاية جلسة التداول يوم 28 ديسمبر الجارى، ويحق له الاكتتاب في حدود 100% من الأسهم التي يمتلكها قبل الزيادة، كما يحق له بيع كل أو جزء من حق الاكتتاب منفصلا عن السهم الأصلى .
وسوف يتم فتح باب الاكتتاب اعتبارا من يوم 31 ديسمبر الجارى وحتى 29 يناير 2015 ويجوز غلق باب الاكتتاب في حالة تغطية كامل قيمة الاكتتاب.
وأعلنت البورصة أنه سيتم الاكتتاب من خلال البنك التجارى الدولى بجميع فروعه بالقاهرة الكبرى والمحافظات.
وافقت الجمعية العامة غير العادية للشركة فى سبتمبر الماضى على زيادة رأس المال بـ 22 مليون جنيه .
كتب : عبدالهادى فوزى